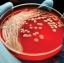

EU-SEARCH NOVICE | Veliki pandemični preobrati, psihotronska orožja, žuželke za kosilo in nove norčije Billa Gatesa ...
 Veliki pandemični preobrati, psihotronska orožja, žuželke za kosilo in nove norčije Billa Gatesa
Veliki pandemični preobrati, psihotronska orožja, žuželke za kosilo in nove norčije Billa Gatesa
(14.05.2023) | newsexchange ...
Nova epizoda Indigo bojevnika tokrat prinaša nekoliko več pozitivnih novic. V Sloveniji je prišlo do precejšnjega preobrata v pandemični zgodbi, tamkajšnja vlada se je odločila državljanom vrniti ... | Podobno 
EU-SEARCH NOVICE | Virolog Billa Gatesa priznal, da "elita" pripravlja nove viruse za začetek leta 2025 - Nato PACT je vključen v vse - Evo, kaj so pripravili ...
 Virolog Billa Gatesa priznal, da "elita" pripravlja nove viruse za začetek leta 2025 - Nato PACT je vključen v vse - Evo, kaj so pripravili
Virolog Billa Gatesa priznal, da "elita" pripravlja nove viruse za začetek leta 2025 - Nato PACT je vključen v vse - Evo, kaj so pripravili
(07.12.2024) | newsexchange ...
Svetovna elita načrtuje sprostitev novega vala smrtonosnih virusov, ki so strateško načrtovani tako, da prekinejo politične dogodke, ohromijo potencialno Trumpovo administracijo in napredujejo v svojem ... | Podobno 
EU-SEARCH NOVICE | Supermarket na Nizozemskem, ki prodaja FAKE MEAT, ki ga financira Fundacija Billa Gatesa, je zagorel ...
 Supermarket na Nizozemskem, ki prodaja FAKE MEAT, ki ga financira Fundacija Billa Gatesa, je zagorel
Supermarket na Nizozemskem, ki prodaja FAKE MEAT, ki ga financira Fundacija Billa Gatesa, je zagorel
(11.07.2022) | newsexchange ...
Podobno 
EU-SEARCH NOVICE | Gensko spremenjeni komarji Billa Gatesa se nezadržno širijo po svetu brez kakršne koli analize ...
 Gensko spremenjeni komarji Billa Gatesa se nezadržno širijo po svetu brez kakršne koli analize
Gensko spremenjeni komarji Billa Gatesa se nezadržno širijo po svetu brez kakršne koli analize
(07.09.2022) | newsexchange ...
Znotraj dvonadstropne opečne stavbe v Medellinu v Kolumbiji znanstveniki delajo v zatohlih laboratorijih in vsak teden v laboratoriju vzredijo 30 milijonov gensko spremenjenih komarjev. Zadovoljujejo ... | Podobno 
EU-SEARCH NOVICE | Se spomnite pobude Billa Gatesa, Agenda ID2020? ...
 Se spomnite pobude Billa Gatesa, Agenda ID2020?
Se spomnite pobude Billa Gatesa, Agenda ID2020?
(14.10.2022) | newsexchange ...
To, s čimer se soočamo zdaj, je veliko hujše. To je Agenda ID2020 na steroidih. To je svetovna invazija s kodo QR – kodiranje QR vsega, vključno z agendo ID2020 – in vseh vaših najbolj intimnih ... | Podobno 
EU-SEARCH NOVICE | Velika trgovska veriga v Veliki Britaniji je začela prodajati žuželke za družine z nizkimi dohodki ...
 Velika trgovska veriga v Veliki Britaniji je začela prodajati žuželke za družine z nizkimi dohodki
Velika trgovska veriga v Veliki Britaniji je začela prodajati žuželke za družine z nizkimi dohodki
(21.10.2022) | newsexchange ...
Črvi, plevel in odpadne vodeBritanski supermarketi zaključujejo načrte za skladiščenje žuželk in njihovo prodajo družinam z nizkimi dohodki, da bi ... | Podobno 
EU-SEARCH NOVICE | Filipini: Izdan nalog za aretacijo Billa Gatesa zaradi "naklepnega umora", povezanega z uvedbo cepiva ...
 Filipini: Izdan nalog za aretacijo Billa Gatesa zaradi "naklepnega umora", povezanega z uvedbo cepiva
Filipini: Izdan nalog za aretacijo Billa Gatesa zaradi "naklepnega umora", povezanega z uvedbo cepiva
(03.03.2023) | newsexchange ...
Sodišče na Filipinih je izdalo mednarodno tiralico za Billa Gatesa, v okviru preiskave o uvedbi cepljenja proti covidu-19 na tem ozemlju.Od začetka cepljenja na Filipinih je število ... | Podobno 
EU-SEARCH NOVICE | Nigerijski uradnik je Billa Gatesa obtožil eksperimentiranja na AFRIČANIH ...
 Nigerijski uradnik je Billa Gatesa obtožil eksperimentiranja na AFRIČANIH
Nigerijski uradnik je Billa Gatesa obtožil eksperimentiranja na AFRIČANIH
(21.04.2023) | newsexchange ...
Visoki nigerijski uradnik je obtožil soustanovitelja Microsofta Billa Gatesa, da uporablja Afričane kot poskusne zajčke za svoje znanstvene poskuse.Priznani znanstvenik dr. Chukwumeria ... | Podobno 
EU-SEARCH NOVICE | Žuželke v hrani niso nič takega, kar so "znanstveniki" šele načrtovali - Fermentirana mikrobna enolončnica za kosilo ...
 Žuželke v hrani niso nič takega, kar so "znanstveniki" šele načrtovali - Fermentirana mikrobna enolončnica za kosilo
Žuželke v hrani niso nič takega, kar so "znanstveniki" šele načrtovali - Fermentirana mikrobna enolončnica za kosilo
(21.04.2023) | newsexchange ...
Zdi se, da v prekrasnem novem svetu ni dovolj jesti le žuželke namesto mesa, zdaj se zdi, da prihajajo tudi bakterije. Prijetno.Verjetno ste že brali o znanstvenikih, ki poskušajo ... | Podobno 
EU-SEARCH NOVICE | ZDA: Smrtonosna malarija registrirana prvič po 20 letih po izdaji gensko spremenjenih komarjev Billa Gatesa ...
ZDA: Smrtonosna malarija registrirana prvič po 20 letih po izdaji gensko spremenjenih komarjev Billa Gatesa
ZDA: Smrtonosna malarija registrirana prvič po 20 letih po izdaji gensko spremenjenih komarjev Billa Gatesa
(01.07.2023) | newsexchange ...
Smrtonosna epidemija malarije je ZDA prvič po več kot dvajsetih letih prizadela po uvedbi kontroverznega projekta Billa Gatesa o gensko spremenjenih komarjih.Pet novih primerov malarije ... | Podobno 
|